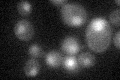
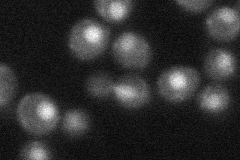

View description
Transcription factor IIIA (TFIIIA), essential protein with nine C2H2 Zn-fingers, binds the 5S rRNA gene through the zinc finger domain and directs assembly of a multiprotein initiation complex for RNA polymerase III; also binds DNA
Localization:
Intensity:
Fold change:
Significance:
-
C’ GFP library in SD
nucleus24.46 -
N' NOP1pr-GFP in SD

nucleus53.1983 -
N' TEF2pr-mCherry in SD

nucleus13.9809 -
N' NATIVEpr-GFP in SD
nucleus27.0627 -
N' TEF2pr-VC and Cyto-VN in SD

nucleus29.6636 -
C’ GFP library in SD+DTT

nucleus19.920.81No -
C’ GFP library in SD+H2O2

nucleus24.861.01No -
C’ GFP library in Starvation Media

nucleus18.030.73Yes -
C’ GFP library on the background of Pup2-DaMP

nucleus -
C’ GFP library on the background of CCT mutant

nucleus24.95221.01988No
